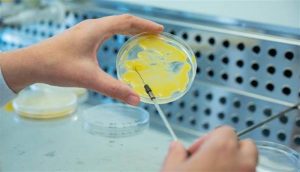
Detalle de trabajo en el laboratorio de la Mision Biologica de Galicia MBG CSIC. Imagen cedida por el Consejo Superior de Investigaciones Cientificas. EFE

El Gobierno negocia «in extremis» con la banca medidas de alivio para hipotecados ante el aumento del euríbor.
Redacción- El Gobierno da por cerrada la negociación con la banca sobre las medidas de alivio para los hipotecados, puesto que ya han sido aprobadas por el Consejo de Ministros